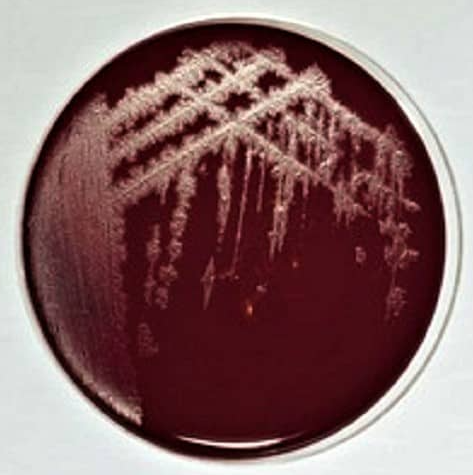
破伤风梭菌培养基基础

破伤风梭菌培养基基础
Clostridium Temtani Medium
询价
500ml
起订
上海 更新日期:2026-04-05
产品详情:
- 中文名称:
- 破伤风梭菌培养基基础
- 英文名称:
- Clostridium Temtani Medium
- 产品类别:
- 培养基
公司简介
齐一生物科技(上海)有限公司,自成立以来经过数年的努力已迅速成为集产品研发、生产、经营为一体的专业化生物工程公司,已成为国内科学试剂的国际运营商之一,是国家重点实验室指定供应商并与国内多家科研单位紧密合作。
| 成立日期 | (12年) |
| 注册资本 | 50万(元) |
| 员工人数 | 1-10人 |
| 年营业额 | ¥ 100万以内 |
| 经营模式 | 贸易,试剂,定制,服务 |
| 主营行业 | 中间体,化学试剂,医药原料 |
破伤风梭菌培养基基础相关厂家报价 更多
-

- 破伤风梭菌培养基基础
- 上海一研生物科技有限公司
- 2026-04-05
- 询价
-

- 梭菌增菌基础培养基
- 上海冠导生物工程有限公司 VIP
- 2026-04-09
- 询价
-

- 梭菌增菌培养基:Clostridium Enrichment Medium
- 上海弘顺生物科技有限公司 VIP
- 2026-04-09
- 询价
-

- 艰难梭菌选择性琼脂培养基基础
- 上海宾穗生物科技有限公司 VIP
- 2026-04-09
- 询价